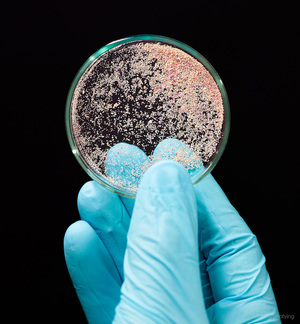

SAND – second album for post-rock solo project
What you may need to know…
01. Keen observers of post-rock/instrumental ongoings may recall North Atlantic Oscillation, an Irish/English/Scottish outfit based in Edinburgh, releasing thru KScope, that came in for serious critical acclaim in the early part of the decade.
02. They’re fronted by Dublin/Limrock man Sam Healy, whose solo project SAND surfaced with a self-titled full-length in 2013, taking NAO’s soundscaping in a more introspective direction.
03. Streaming above is Seldom-Used Furniture, taken from SAND’s newly-released sophomore effort, A Sleeper, Just Awake.
04. The album is available now on CD and digital. Meanwhile, fans of Healy’s mothership will be happy to learn that a compilation of the band’s tunes is also up for pre-order at present via the band’s site.
VERDICT: Arriving at a mad intersection of post-rock, prog, psychedelia and taking on inflections of jazz, SAND plays with the various boundaries and lines between them all, to glorious effect.
SAND